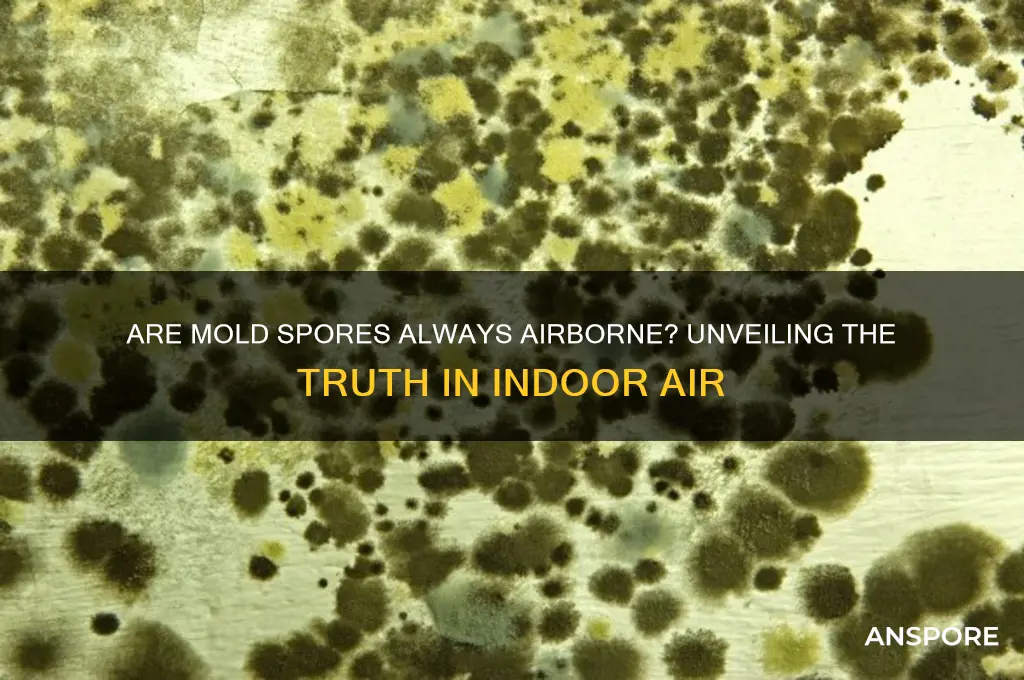
are mold spores always in the air

Mold spores are a ubiquitous presence in both indoor and outdoor environments, and it is virtually impossible to eliminate them entirely from the air. These microscopic particles are naturally occurring and play a crucial role in the decomposition of organic matter. While mold spores are always present in the air to some extent, their concentration can vary significantly depending on factors such as humidity, temperature, and the presence of mold growth in the surrounding area. Understanding the prevalence of mold spores in the air is essential, as elevated levels can pose health risks, particularly for individuals with allergies, asthma, or compromised immune systems. Therefore, recognizing the conditions that promote mold spore proliferation and implementing effective air quality management strategies are vital steps in maintaining a healthy living environment.
| Characteristics | Values |
|---|---|
| Presence in Air | Mold spores are always present in the air, both indoors and outdoors. |
| Concentration | Outdoor spore counts are typically higher than indoor counts, but indoor levels can increase due to moisture issues. |
| Sources | Outdoor sources include soil, plants, and decaying organic matter; indoor sources include damp materials like walls, carpets, and HVAC systems. |
| Viability | Most spores in the air are dormant but can become active and grow when they land on suitable surfaces with moisture. |
| Health Impact | Generally harmless in low concentrations, but high levels can cause allergic reactions, respiratory issues, and other health problems, especially in sensitive individuals. |
| Detection | Air sampling and surface testing can measure spore concentrations; visible mold or musty odors often indicate higher levels. |
| Prevention | Maintaining low indoor humidity (below 60%), fixing leaks, and proper ventilation can reduce indoor spore levels. |
| Seasonal Variation | Outdoor spore counts vary by season, typically peaking in late summer and fall when conditions are warm and humid. |
| Indoor vs. Outdoor | Indoor spore types may differ from outdoor types, with indoor molds often including species like Cladosporium, Penicillium, and Aspergillus. |
Explore related products
What You'll Learn

Natural occurrence of mold spores
Mold spores are ubiquitous in the natural environment, floating in the air both indoors and outdoors. These microscopic particles are a natural part of the ecosystem, playing a crucial role in the decomposition of organic matter. Unlike pollutants or allergens that can be eliminated, mold spores are ever-present, making their management, rather than eradication, the focus of healthy living. Understanding their natural occurrence is the first step in mitigating potential health risks.
Consider the lifecycle of mold spores to grasp their persistence. Mold thrives in damp, humid conditions, breaking down dead plants, leaves, and wood in forests and fields. This process releases spores into the air, where they travel on currents, settling in new locations to repeat the cycle. Outdoor spore counts vary by season, peaking in warm, humid months when conditions are ideal for mold growth. For instance, a study in the *Journal of Allergy and Clinical Immunology* found that outdoor mold spore concentrations can exceed 50,000 spores per cubic meter during fall in temperate climates.
Indoors, mold spores enter through open windows, doors, and HVAC systems, or hitch a ride on clothing and pets. While not all spores find the moisture needed to grow, their presence is inevitable. A well-maintained home with humidity below 50% can prevent spore germination, but it cannot eliminate spores entirely. Practical steps include using dehumidifiers in basements and bathrooms, fixing leaks promptly, and ensuring proper ventilation in kitchens and laundry rooms.
Comparing outdoor and indoor environments highlights the importance of context. Outdoors, high spore counts are diluted by open space, posing minimal risk to healthy individuals. Indoors, however, confined spaces can concentrate spores, particularly in poorly ventilated areas. For example, a bedroom with a leaky roof may harbor mold colonies, releasing spores that accumulate over time. Vulnerable populations, such as those with asthma or allergies, may experience symptoms at spore levels as low as 1,000 spores per cubic meter, according to the EPA.
To manage indoor spore levels, adopt a proactive approach. Regularly clean air filters, vacuum with HEPA filters, and monitor humidity levels. In high-risk areas like basements, consider using mold-resistant products during renovations. While complete spore removal is impossible, controlling their environment reduces the likelihood of mold growth and associated health issues. By understanding the natural occurrence of mold spores, individuals can take informed steps to coexist with them safely.
Can Lysol Spray Effectively Eliminate Airborne Mold Spores in Your Home?
You may want to see also

Indoor vs. outdoor spore concentration
Mold spores are ubiquitous, but their concentration varies significantly between indoor and outdoor environments. Outdoors, mold spores are part of the natural ecosystem, with levels fluctuating based on factors like humidity, temperature, and vegetation. For instance, outdoor spore counts can range from 500 to 5,000 spores per cubic meter of air, depending on the season and location. These spores are typically dispersed by wind and rain, contributing to their relatively uniform distribution in open spaces.
Indoors, however, spore concentration is heavily influenced by human activity and environmental conditions. Poor ventilation, water damage, and high humidity can cause indoor spore counts to skyrocket, often exceeding outdoor levels by several orders of magnitude. Studies have shown that indoor spore concentrations can reach up to 10,000 spores per cubic meter in damp or mold-prone areas, posing health risks, especially for individuals with allergies or respiratory conditions. For example, a bathroom with persistent moisture issues may harbor Cladosporium or Aspergillus spores, which thrive in damp environments.
To mitigate indoor spore concentration, practical steps include maintaining indoor humidity below 50%, promptly fixing leaks, and using exhaust fans in kitchens and bathrooms. HEPA air purifiers can also reduce airborne spores, particularly in enclosed spaces. For households with children or elderly individuals, who are more susceptible to mold-related health issues, regular mold inspections and spore testing are recommended. DIY spore test kits are available for under $50 and provide actionable data to guide remediation efforts.
Comparatively, outdoor spore management is less about control and more about awareness. While outdoor spores are generally harmless in low to moderate concentrations, individuals with mold sensitivities should monitor local spore counts, especially during peak seasons like fall. Apps and websites like Pollen.com offer real-time spore data, allowing users to plan outdoor activities accordingly. For gardeners or farmers, rotating crops and reducing organic debris can minimize spore proliferation in specific areas.
Ultimately, understanding the disparity between indoor and outdoor spore concentration empowers individuals to take targeted action. While outdoor spores are an unavoidable aspect of the environment, indoor levels are largely within human control. By addressing moisture sources, improving airflow, and leveraging technology, households can maintain spore counts comparable to—or even lower than—outdoor levels, fostering healthier living spaces.
Are Botulism Spores Airborne? Unraveling the Truth and Risks
You may want to see also

Health risks of airborne spores
Mold spores are omnipresent in both indoor and outdoor environments, but their concentration and type determine potential health risks. While most people inhale these microscopic particles daily without issue, certain groups are more vulnerable to their effects. Individuals with compromised immune systems, respiratory conditions like asthma, or allergies are at higher risk. For example, prolonged exposure to elevated levels of *Aspergillus* or *Stachybotrys* spores can exacerbate existing health issues or trigger new symptoms. Understanding the specific risks associated with airborne spores is crucial for targeted prevention and mitigation.
One of the most immediate health concerns linked to airborne mold spores is allergic reactions. Symptoms can range from mild, such as sneezing and itchy eyes, to severe, like difficulty breathing or asthma attacks. Studies show that indoor mold spore concentrations above 1,000 spores per cubic meter significantly increase the likelihood of allergic responses, particularly in children and the elderly. Practical steps to reduce exposure include using HEPA air filters, maintaining indoor humidity below 50%, and promptly addressing water leaks or dampness in homes. These measures can effectively lower spore counts and minimize allergic reactions.
Beyond allergies, airborne mold spores can pose serious risks to respiratory health, especially in individuals with pre-existing conditions. For instance, *Aspergillus* spores can cause aspergillosis, a fungal infection that ranges from mild allergic reactions to severe invasive disease in immunocompromised individuals. Similarly, prolonged exposure to *Stachybotrys*, often referred to as "black mold," has been linked to chronic respiratory issues and, in rare cases, toxic effects. Monitoring indoor air quality and avoiding environments with visible mold growth are essential steps to protect respiratory health. Regularly inspecting areas prone to moisture, such as basements and bathrooms, can prevent spore proliferation.
A lesser-known but significant risk of airborne mold spores is their potential to exacerbate mental health issues. Research suggests a correlation between mold exposure and symptoms of anxiety, depression, and cognitive impairment, particularly in individuals with mold sensitivities. Mycotoxins produced by certain molds, such as *Penicillium* and *Fusarium*, may contribute to these effects. To mitigate this risk, ensure proper ventilation in living spaces, avoid carpeting in damp areas, and use dehumidifiers in humid climates. Addressing mold-related mental health concerns often requires a multidisciplinary approach, including environmental remediation and medical intervention.
In conclusion, while mold spores are a natural part of the environment, their health risks should not be underestimated. By understanding the specific dangers associated with different spore types and concentrations, individuals can take proactive steps to protect themselves and their families. From reducing allergic reactions to preventing severe respiratory infections and addressing mental health impacts, targeted strategies can significantly improve indoor air quality and overall well-being. Awareness and action are key to minimizing the health risks of airborne spores.
Are Magic Mushroom Spores Legal in Nevada? Exploring the Law
You may want to see also
Explore related products

Factors affecting spore presence
Mold spores are ubiquitous in both indoor and outdoor environments, but their concentration and persistence in the air are not constant. Understanding the factors that influence spore presence is crucial for managing air quality and mitigating health risks. One primary factor is humidity, as mold thrives in environments with relative humidity above 60%. In regions with high ambient moisture or poorly ventilated spaces, spore counts can spike dramatically. For instance, bathrooms and basements often harbor higher spore levels due to their damp conditions. To combat this, maintaining indoor humidity below 50% with dehumidifiers or proper ventilation can significantly reduce spore proliferation.
Another critical factor is seasonal variation. Outdoor mold spore concentrations tend to peak during late summer and early fall, coinciding with decaying plant matter and warmer temperatures. This seasonal surge can infiltrate indoor spaces through open windows or HVAC systems, particularly in areas with high vegetation. Monitoring local spore forecasts and using HEPA filters during peak seasons can help minimize indoor exposure. For allergy sufferers, staying indoors during early mornings—when spore counts are highest—may provide relief.
Building materials and age also play a significant role in spore presence. Older structures with water damage, leaky roofs, or inadequate insulation are breeding grounds for mold. Materials like drywall, carpet, and wood are particularly susceptible to colonization when exposed to moisture. Regular inspections for water intrusion and prompt repairs are essential preventive measures. In new constructions, using mold-resistant materials and ensuring proper waterproofing can reduce the risk of spore accumulation over time.
Lastly, human activities can inadvertently increase spore levels. Activities such as showering, cooking, and even houseplants introduce moisture into the air, creating conditions conducive to mold growth. Poor housekeeping practices, like neglecting to clean damp areas, further exacerbate the problem. Simple habits like wiping down wet surfaces, using exhaust fans, and regularly cleaning air filters can make a substantial difference. For households with pets, grooming and cleaning pet areas frequently can prevent mold from thriving on dander and fur.
In summary, while mold spores are ever-present, their airborne concentration is dictated by a combination of environmental and human factors. By addressing humidity, seasonal changes, building integrity, and daily habits, individuals can effectively manage spore levels and maintain healthier indoor air quality.
Does Sterilization Kill Spores? Unraveling the Science Behind Effective Disinfection
You may want to see also

Methods to reduce airborne spores
Mold spores are ubiquitous, floating in the air both indoors and outdoors. While complete eradication is impossible, reducing their presence is achievable through targeted strategies. One effective method is maintaining optimal humidity levels, as mold thrives in damp environments. Invest in a hygrometer to monitor indoor humidity, aiming for levels below 50%. Dehumidifiers are invaluable in high-moisture areas like basements or bathrooms, but ensure they’re regularly emptied and cleaned to prevent becoming spore sources themselves.
Another critical approach is improving air circulation. Stagnant air allows spores to settle and multiply. Use exhaust fans in kitchens and bathrooms to expel moisture, and open windows periodically to promote airflow. Air purifiers equipped with HEPA filters can also trap airborne spores, though they should complement, not replace, other measures. For maximum efficiency, place purifiers in high-traffic areas or rooms prone to moisture, such as bedrooms or laundry rooms.
Cleaning practices play a pivotal role in spore reduction. Regularly vacuum carpets, upholstery, and curtains using a vacuum with a HEPA filter to prevent spore recirculation. Hard surfaces should be wiped with a solution of water and detergent, followed by a mold-inhibiting agent like vinegar or hydrogen peroxide. Avoid carpeting in moisture-prone areas, opting instead for tile or hardwood, which are easier to keep dry and clean.
Finally, address the root cause: moisture intrusion. Inspect homes for leaks in roofs, pipes, or windows, and repair them promptly. Ensure proper drainage around foundations and slope landscaping away from the house. In humid climates, consider using mold-resistant products like paints and drywall during construction or renovation. These proactive steps not only reduce airborne spores but also prevent mold colonies from establishing in the first place.
By combining these methods—humidity control, air circulation, diligent cleaning, and moisture prevention—individuals can significantly lower airborne spore counts, fostering healthier indoor environments. While spores will always be present, their impact can be minimized with consistent effort and strategic interventions.
Are Fern Spores Dangerous? Uncovering the Truth About These Tiny Particles
You may want to see also
Frequently asked questions
Yes, mold spores are naturally present in both indoor and outdoor air at varying levels.
Mold spores can trigger allergic reactions, asthma, or respiratory issues in sensitive individuals, especially when present in high concentrations.
Yes, all indoor environments have some level of mold spores, but the concentration varies based on factors like humidity, ventilation, and cleanliness.
No, it’s impossible to completely eliminate mold spores from the air, but their levels can be managed through proper ventilation, humidity control, and air filtration.
Outdoor mold spore levels are generally higher than indoor levels, especially in damp or humid environments, but indoor levels can spike if mold growth occurs inside.

























